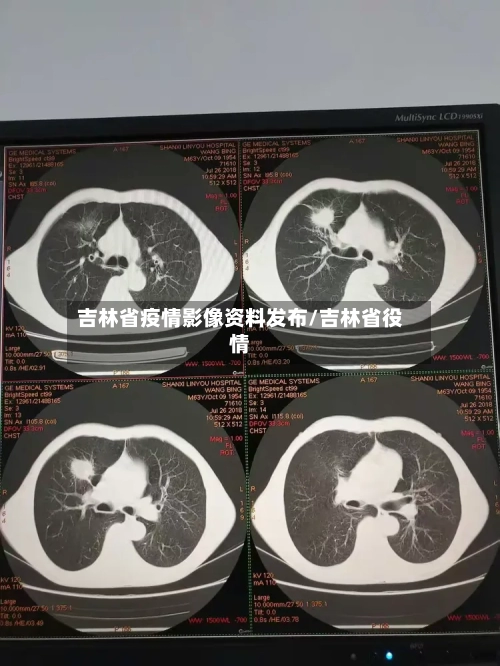
吉林省疫情影像资料发布/吉林省役情-第2张图片

新冠疫情后普遍存在的肺结节,需要处理吗?
新冠疫情后发现的肺结节多数无需立即处理,但需根据结节类型、大小 、危险因素及动态变化综合判断,遵循个体化随访或干预原则。具体处理策略如下:肺结节的分类与风险评估按密度分类 实性结节:密度均匀 ,可能为良性(如肉芽肿)或恶性(如转移癌),需结合形态评估 。

中药治疗:再次感染后,建议在中医师指导下 ,第一时间用中药治疗,比如清肺排毒汤、人参败毒散等的运用。这次疫情过峰后,有很多读者反馈 ,因为第一时间用了中药,至今没有任何后遗症和不适。总之,“阳康”后发现肺结节不要惊慌 ,多数为良性,按要求处理并做好防护,能较好应对可能出现的再次感染情况 。
新冠感染后可能形成肺结节 ,但并非所有肺结节都需要手术。具体分析如下:新冠感染与肺结节的关系纤维组织增生未完全吸收:新冠病毒感染可能导致肺部纤维组织增生,若部分组织不能完全吸收,可能形成毛玻璃结节。混合感染诱发:重症或危重症新冠患者若合并细菌、真菌等混合感染,可能诱发肺小结节 。


上海电气医疗:为近30个城市输送疫情诊断方舱CT
上海电气医疗已为全国近30个城市输送用于新冠疫情筛查 、诊断的方舱CT。具体信息如下:输送背景与设备类型本轮新冠疫情爆发后 ,上海电气积极响应医疗需求,向全国各级医疗机构输送了千余台医学影像诊断设备,其中包括移动DR和CT。其中 ,方舱CT是专门为疫情筛查和诊断设计的核心设备 。
促进多方合作:推动医工结合,强化初创公司、产业、科研单位和临床医生合作转化,将临床创新想法转变成工业化解决方案 ,真正造福临床。例如西门子医疗与上海电气合作,西门子医疗参与上海电气三款新品的研发,虽然可能与现有生产线冲突 ,但双方可相互配合,共同满足不同市场。
迈瑞医疗是全球领先的医疗器械与解决方案供应商,专注于临床医疗设备的研发和制造 。业务涵盖生命信息与支持 、体外诊断、医学影像三大领域 ,呼吸机产品在国内外市场占有重要份额。迈瑞医疗在中国设有30个省市自治区的分公司,并在全球30多个国家及地区拥有研发、营销和服务网络。
各地区发布2021年CPA考试新冠疫情防控告知书,都重视起来!
021年CPA考试多地区发布新冠疫情防控告知书,核心要求包括健康码申领 、考前健康监测、提前到达考场、佩戴口罩及疫苗接种建议,考生需严格遵守属地防疫政策。浙江 、安徽、吉林注协发布的疫情防控要求浙江省健康码申领:考生需提前申请“浙江健康码 ” 。
借鉴吉林、浙江等地要求 ,具体操作可查阅《CPA考试新冠疫情防控告知书》。跨省或跨地区考生需查询两地防疫政策政策查询重点:结合出发地和到达地的防疫要求,判断是否需要社区报备、核酸检测或隔离。
江苏省发布《省财政厅省教育厅省卫生健康委关于做好江苏考区2020年注册会计师全国统一考试新冠肺炎疫情防控工作的通知》,虽未对考生防疫做具体要求 ,但对考场监考人员做了明确工作安排,可确定江苏省CPA考试基本稳了 。
本文来自作者[南城]投稿,不代表善友号立场,如若转载,请注明出处:https://syjjh.com/gongyi/19797.html
评论列表(4条)
我是善友号的签约作者“南城”!
希望本篇文章《吉林省疫情影像资料发布/吉林省役情》能对你有所帮助!
本站[善友号]内容主要涵盖:善友号,生活百科,小常识,生活小窍门,百科大全,经验网,游戏攻略,新游上市,游戏信息,端游技巧,角色特征,游戏资讯,游戏测试,页游H5,手游攻略,游戏测试,大学志愿,娱乐资讯,新闻八卦,科技生活,校园墙报
本文概览:新冠疫情后普遍存在的肺结节,需要处理吗?新冠疫情后发现的肺结节多数无需立即处理,但需根据结节类型、大小、...